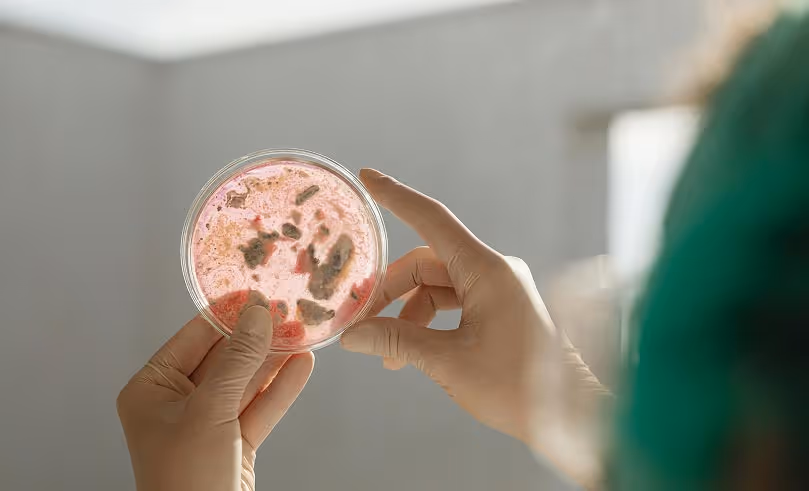
Gloved hands holding a petri dish with red and brown bacterial cultures against a blurred background.

Enterprise
Data infrastructure that scales across your organization
Labric provides enterprise-grade data infrastructure that breaks down silos across departments and facilities, scaling with your organization while maintaining the flexibility researchers need.



Scale your research operations across departments
Organization-wide visibility
Centralized access to research data across all departments and facilities, enabling insights that span projects and teams.
Governed collaboration
Role-based access and data governance policies ensure the right people have access while maintaining compliance.
Enterprise integrations
Connect to your existing infrastructure including LIMS, ELN systems, data warehouses, and business intelligence tools.
One source of truth for all research data
Cross-department data access
Researchers discover and leverage data from other teams while maintaining proper security and access controls.
Centralized governance policies
Set organization-wide standards for data retention, access, and compliance that cascade automatically with department-specific flexibility.
Independent yet connected
Labs share infrastructure without sharing data. Each team maintains custom schemas and workflows that fit their science.

Enterprise-grade security and compliance
Labric provides the security controls and certifications required for regulated research environments.
SOC 2 Type II certification in progress
SSO integration with multi-factor authentication
Complete audit logging with user attribution
Cloud-hosted, hybrid, or on-premise deployment options

Integrate with your existing infrastructure
Choose your deployment
Choose full cloud for simplicity, hybrid for specific data residency needs, or fully on-premise for maximum control over your infrastructure.
Enterprise system integration
Bi-directional sync with LIMS, ELN systems, and data warehouses plus API access for custom integrations with your internal tools.
Bring your own infrastructure
Use your preferred cloud provider and LLM models with full control over where data is processed and stored.
Built to handle your largest workloads
Petabyte scale
Handle massive datasets from high-throughput instruments with storage that scales automatically.
Unlimited users
Support thousands of concurrent users without performance degradation or bottlenecks.
Global access
Multi-region deployment ensures low-latency access for facilities worldwide.
99.9% uptime
Enterprise SLA with automated failover and disaster recovery.
Use cases
Built for research at any scale
Multi-site pharmaceutical R&D

Coordinate drug discovery globally
Unify data from chemistry, biology, and manufacturing teams across sites while maintaining regulatory compliance.
Advanced materials manufacturing

Connect R&D to production
Track materials from initial R&D experiments through pilot production to full-scale manufacturing.
Enterprise biotechnology
Accelerate therapeutic development
Centralize data across protein engineering, cell line development, and process optimization programs.
20x
faster experimental cycle times vs. traditional solutions
300+
instruments supported for automatic data ingestion
8 seconds
median time to stream and process new data


Support
Dedicated resources for enterprise organizations
Dedicated success team
Assigned customer success manager who understands your organization and workflows.
24/7 enterprise support
Around-the-clock support with guaranteed SLA response times and priority escalation for critical issues.
Training & onboarding
Comprehensive training for administrators, researchers, and power users with ongoing education as new features launch.
Frequently asked questions
- We start with a 1–2 week scoping phase to map your instruments, data sources, and workflows across all sites.
- Rollout is modular. We deploy site-by-site or department-by-department so you see value quickly without disrupting ongoing research.
- Our lightweight Sync app is installed on lab computers at each site. No heavy IT infrastructure changes needed.
- Labric supports cloud, hybrid, or on-premise deployment so your data stays exactly where your policies require.
- All data is encrypted in transit and at rest. SOC 2 Type II certification is underway, and we provide full compliance documentation on request.
- You can bring your own LLM provider to ensure sensitive research data never leaves your approved infrastructure.
- 24/7 priority support with guaranteed SLA response times and a dedicated customer success manager.
- Hands-on onboarding, custom schema design, and ongoing optimization as your research needs evolve.
- Priority access to new features and direct input into our product roadmap.
- Yes. Most enterprise customers begin with a focused pilot, typically one team or one lab, to validate the platform against their workflows.
- Pilots run about 3 months and include full platform access, instrument syncing, custom schema design, and dedicated support.
- No long-term commitment required. We want you to see real results before scaling.
- No. You retain full access to your instrument parsers, data models, and up-to-date backups of all your experimental data.
- Your data is stored in standard, portable formats and can be exported at any time.
